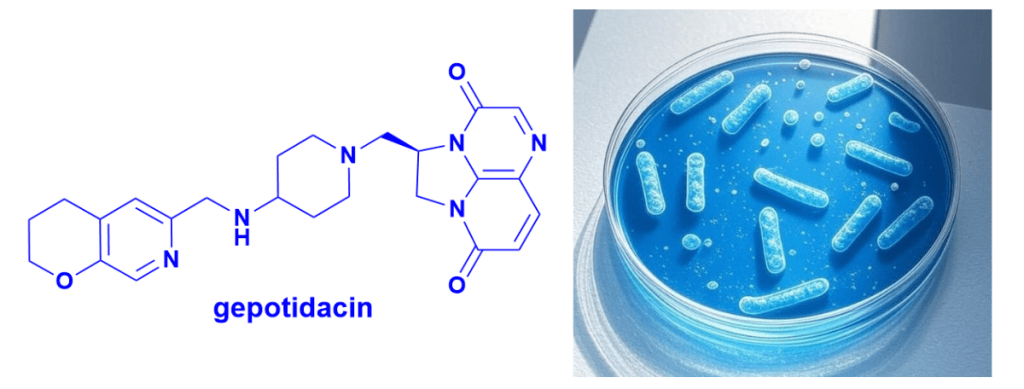

Continuing on my blog posts on natural products, antibiotics and other topics…
💠 During World War II, both Allied and Axis forces used stimulants like amphetamine and methamphetamine to maintain alertness in combat. But another related compound—fenethylline, better known as Captagon—has taken a darker path in recent decades. Amphetamine ties back to natural products through the exploration of chemistry around ephedrine, originally isolated from Ephedra sinica in the 1880s. I will expand upon this link in a later blog.
💠 Developed in the early 1960s, fenethylline is a co-drug of amphetamine and theophylline, joined by an ethane bridge. It was originally prescribed for hyperkinesis (now ADHD), narcolepsy, and depression, often preferred over amphetamines for its more tolerable profile. Its clinical use was short-lived, however—it was banned in most countries by 1986 following WHO’s inclusion under the Convention on Psychotropic Substances.
💠 Pharmacologically, fenethylline is more lipophilic, enabling rapid absorption into the CNS. It metabolises into amphetamine (24.5%) and theophylline (13.7%, caffeine related compound), working synergistically: amphetamine boosts dopamine signalling as a potent stimulant, while theophylline provides weaker stimulation and bronchodilation.
💠 Though long out of medical use, fenethylline re-emerged on the black market, produced in clandestine labs across the Middle East and Southern Europe. It has since been linked to recreational and combat use—highlighting drug misuse in modern conflict zones.
🧪 This is a potent example of how drugs can be redirected far from their original therapeutic intent.

#MedicinalChemistry #Neuropharmacology #ControlledSubstances #DrugMisuse #HistoryOfMedicine #ConflictZones #ScienceCommunication